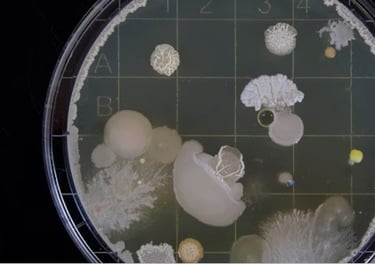

Saúde
Dicas e informações sobre saúde
Os benefícios do jejum intermitente
Os Benefícios da corrida
O que é o Ho'oponopono?
A Revolução da Moda: Monjaro e Ozempic em Alta
Qual a importância da gratidão
Bactérias na Bucha de Prato: O Que Você Precisa Saber e Como Se Proteger
Você Sabe de Quantas Calorias Precisa Apenas Para Viver?
A Nova Virose, na verdade não é tão nova assim.
Os Benefícios dos Chás
O Brasil da Losartana
Tadalafila: O Remédio para Ereção que Virou Febre no Pré-Treino
Como os Músculos da Perna Podem Prevenir Doenças
Jejum intermitente